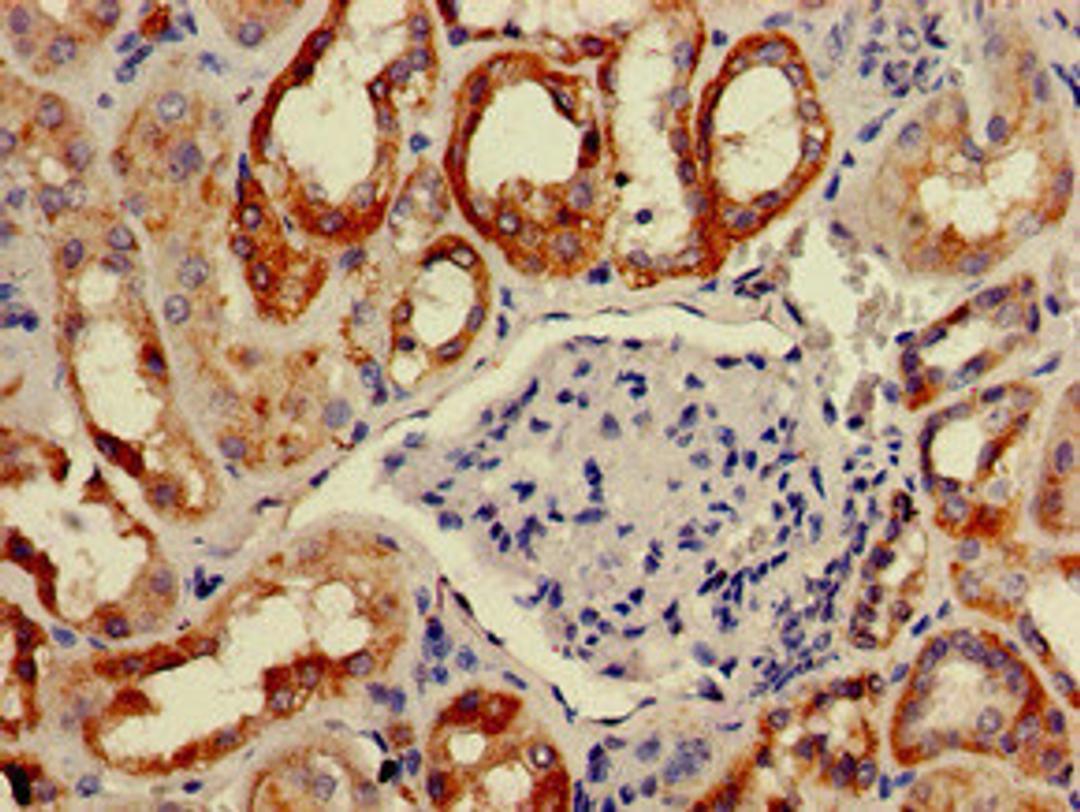
Immunohistochemistry of paraffin-embedded human kidney tissue using CSB-PA891988LA01HU at dilution of 1:100

Product & ReviewsAntibodies
BAIAP2 Antibody
Product Details
- Cat. No.
- CSB-PA891988LA01HU
- Type
- Primary Antibody
- Clonality
- Polyclonal
- Host
- Rabbit
Reviews
Applications
- ELISA (ELISA)
- Western Blotting (WB)
- Immunohistochemistry (IHC)
- Immunofluorescence (IF)